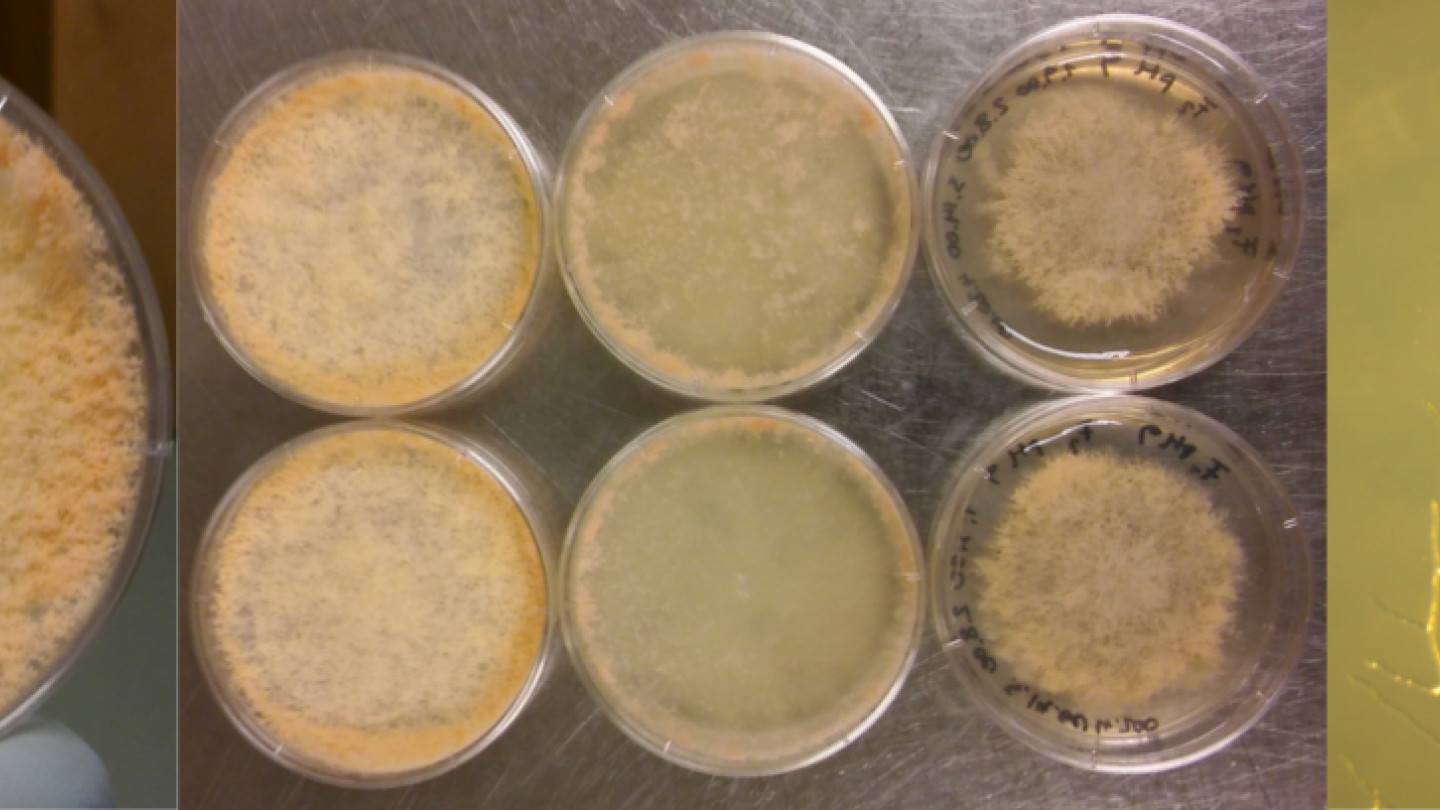

Table of contents



Research group description
We have a rather good understanding on how natural selection works. However, our understanding of how variation is generated is much more limited. In order to have ha complete theory of evolutionary adaptation we need to to understand the properties of mutations. In the Genetics, epigenetics, and evolution group we study the properties of genetic mutations and epigenetic changes. We are interested in understanding the distribution of fitness effects of different types of mutations or epigenetic changes, and how the properties of epigenetic changes differ from genetic mutations.
We are using mainly the filamentous fungus Neurospora crassa and the fission yeast Schizosaccharomyces pombe as study systems. We study the properties of spontaneous mutations using mutation accumulation experiments, experimental evolution, genomics, methods of genetic mapping.